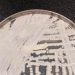
Fiocruz e Pasteur vão pesquisar sobre danos dos fungos no ser humano

A proposta da Reforma Tributária pode triplicar a tributação cobrada no setor de serviços. A matéria está sob análise da Câmara dos Deputados e deve ser votada no início de julho, segundo anunciou o presidente da Casa, Arthur Lira (PP).
Atualmente o setor de serviço é onerado a partir do ISS (Imposto sobre Serviços, que é municipal), PIS e Cofins (tributos federais). Nas sociedades profissionais, que englobam profissões como médico, arquiteto, advogado, o ISS é fixo desde 1960, e em regra geral é de 5%. Somado esse tributo ao PIS e Cofins, a classe paga uma taxa média de 8,65%.
No entanto, a reforma prevê a criação do imposto sobre valor agregado (IVA), que pretende unificar os tributos estaduais e municipais. Apesar do plano ser de simplificação do sistema de impostos, o IVA tem valor de referência de 25%, o que pode fazer saltar a contribuição dos profissionais do setor de serviços de 8,65% para 25% .
A mudança afeta principalmente o grupo que opta pelo Imposto de Renda pelo lucro presumido. Sendo que o sistema de microempreendedores não está envolvido nas alterações da reforma.
Fonte Metro1